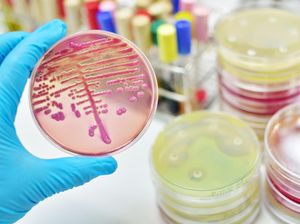
Kerap Disebut Sumber Penyakit, Ini Peran Penting Bakteri dalam Kehidupan Kerap Disebut Sumber Penyakit, Ini Peran Penting Bakteri dalam Kehidupan

detikFinanceSelasa, 05 Sep 2023 11:28 WIB
detikFinanceSelasa, 05 Sep 2023 11:28 WIB
Bakal Ada Pembangkit Biogas di Bandung, Bahan Bakunya dari Kotoran-Limbah Pabrik
PT Rukun Raharja Tbk (RAJA) melalui anak usahanya yaitu PT Energasindo Heksa Karya (EHK) akan mengembangkan pembangkit listrik Biogas di Bandung.